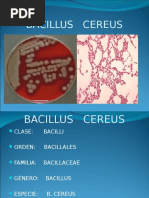

0% encontró este documento útil (0 votos)
508 vistas6 páginasBacillus Cereus PDF
Este documento describe los procedimientos para realizar un recuento de Bacillus cereus en alimentos. Incluye la identificación de la técnica de recuento, los fundamentos de los medios de cultivo utilizados para el aislamiento y confirmación de B. cereus mediante pruebas bioquímicas, y el análisis e interpretación de los resultados obtenidos en los recuentos de diferentes tipos de alimentos en comparación con las normas vigentes.
Cargado por
Angela SuarezDerechos de autor
© © All Rights Reserved
Nos tomamos en serio los derechos de los contenidos. Si sospechas que se trata de tu contenido, reclámalo aquí.
Formatos disponibles
Descarga como PDF, TXT o lee en línea desde Scribd
0% encontró este documento útil (0 votos)
508 vistas6 páginasBacillus Cereus PDF
Este documento describe los procedimientos para realizar un recuento de Bacillus cereus en alimentos. Incluye la identificación de la técnica de recuento, los fundamentos de los medios de cultivo utilizados para el aislamiento y confirmación de B. cereus mediante pruebas bioquímicas, y el análisis e interpretación de los resultados obtenidos en los recuentos de diferentes tipos de alimentos en comparación con las normas vigentes.
Cargado por
Angela SuarezDerechos de autor
© © All Rights Reserved
Nos tomamos en serio los derechos de los contenidos. Si sospechas que se trata de tu contenido, reclámalo aquí.
Formatos disponibles
Descarga como PDF, TXT o lee en línea desde Scribd